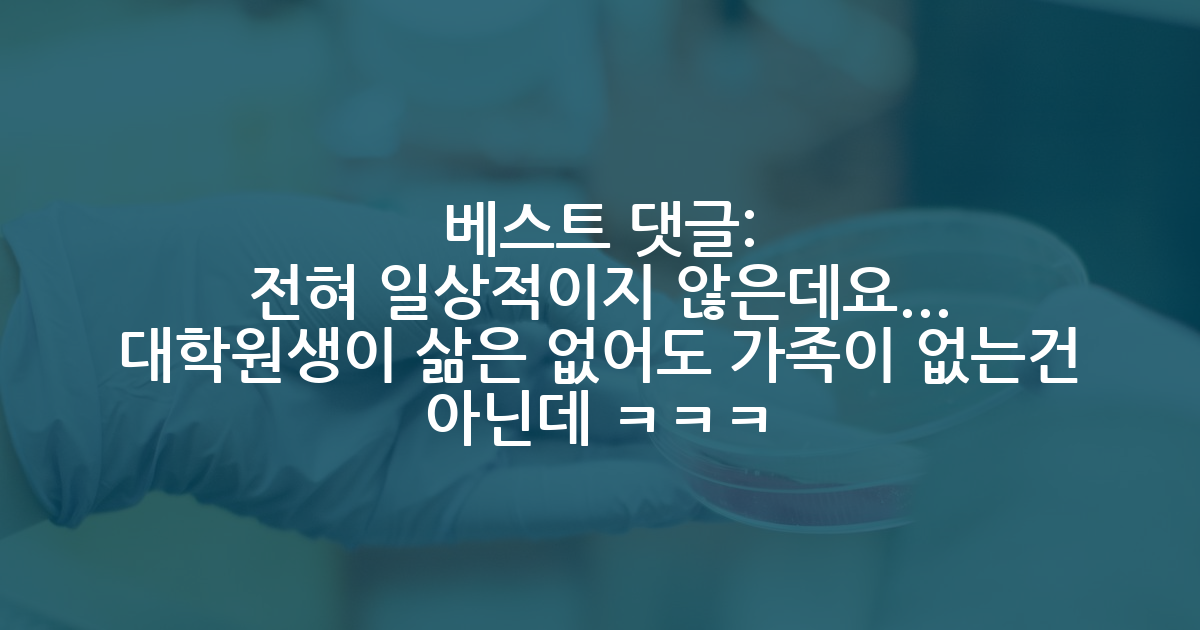

카카오 계정과 연동하여 게시글에 달린
댓글 알람, 소식등을 빠르게 받아보세요
가장 핫한 댓글은?
- 교수 ㅈㄴ 어이없네요.. 방학때 통으로 쉬다오는 애들도 널렸는데 인건비 안받고 일까지 하겠다는데 그걸 왜 아니꼬와하지..? 교수입장에선 여름 인건비 아끼고 일은 일대로 시키고 개꿀인 상황인데.
여름에 통으로 못가게 된다면 저라면 일단 2주 다녀오고 나서 자주 화상통화 드릴거같아요.
저도 한국에선 같은 땅에 있다는 이유로 연락을 잘 안하게 되는데, 유학중인 지금은 매주 화상통화 드려요. 직접 뵈진 못하지만 그래도 의무감으로 오히려 더 자주 연락드리게되는 장점(?)은 있네요.
입원중이시면 병원에서 적적하실텐데 매일 화상통화라도 드려보시는건 어떨까요?
1년차 박사과정인데 어머니가 아프시다는 소식을 들었습니다
24 - 가장 먼저, 얼마나 무거운 마음이실지 감히 짐작도 되지 않아 마음이 많이 아픕니다.
(저 역시 해외 박사과정 중에 많은 가족들의 장례식에 참여하지 못해 조금이지만 그 마음을 이해합니다.)
시간이 허락한다면 다음 학기에 휴학을 하고 한국에 다녀오시는 것이 가장 좋겠지만, 현실적으로 쉽지 않다면 가능한 한 빠르게 한국에 들어가셔서 가족분들과 시간을 보내시는 것도 한 방법이 아닐까 조심스럽게 생각해 봅니다.
물론 어떤 선택을 하시든 전적으로 개인의 결정이기에 제가 감히 말씀드리기 조심스럽지만, 가족이라는 가치를 중요하게 생각하는 입장에서는 저라면 마지막 시간을 함께하는 쪽을 선택할 것 같습니다.
어떤 결정을 하시든 그 선택이 가장 최선의 선택이 되실 거라 믿습니다. 진심으로 응원하고 있습니다.
1년차 박사과정인데 어머니가 아프시다는 소식을 들었습니다
14 - 여름에 남아서 연구한다 쳐도 손에 잡힐까요...
1년차 박사과정인데 어머니가 아프시다는 소식을 들었습니다
14 - 교수가 싸패인거같은데 작성자분들 곱게 졸업시켜줄까요? 그거부터 의문이 드는데요
1년차 박사과정인데 어머니가 아프시다는 소식을 들었습니다
13 - 제가 그 상황에 있다고 생각하고 말씀드리면, 혹여나 부모님께서 안좋은 상황이 왔을때 그 상황에서 저는 100% '부모님 대신에 박사를 선택했다'라는 마음이 구석탱이에 한평생 남을 것 같습니다... 제 의견이 선택에 도움이 될지는 모르겠지만, 어떤 선택이든 부모님 옆에 최대한 있을 수 있는 쪽으로 선택이 되었으면 좋겠습니다.
1년차 박사과정인데 어머니가 아프시다는 소식을 들었습니다
10 - 이런 교수같지도 않은 새끼들 다 짤라서 신임교수 to 내야함
교수새키 애들 속이는거 너무 못됫음
16 - 방치라는 표현은 좀 부적절한듯.
원래 대학원부터는 자기가 적극적으로 나서서 자기 먹을거 찾아먹어야되. 걍 가만히 있으면 알아서 챙겨주겠지 생각하면 너무 착각하고 있는 것 같아
n개월째 방치 중인 학부연구생, 이대로 탈출해도 될까요?
6 - 대학원은 직장이 아니에요. 님 보험 실비 통신비 생활비 하고싶은거 다하고 지낼수있게 돈주는 곳은
더더욱 아니구요.
이공계 석사 인건비 평균일까요?
6 - 근데 어차피 그 등록금만큼 까서 최소로 주는 분들이 태반인데 고마울거 없어요
나라에서 여러 과기원들을 만들어준게 너무 감사하네요
6 - 찾아와서 그간 살아온 인생과 추천서에 쓰여질 말들을 소상히 설명하고 설득하라고 하면 어떨까요? 그 학생도 비정상적인 요청임을 알테니 그 정도 성의는 보여야 하지 않을까요? 그것도 못한다면 애초에 추천서가 절실한 것도 아닐테고요.
10년 만에 학부 강의를 1개 들은 학생이 추천서 를 메일로 요청해 왔습니다.
16 - “저희 학교 최종 졸업이 아니어서요” -> 3
옮긴 학교에서 추천서 써줄 사람을 못찾았을 정도면 솔직히 교수 입장에서도 이 학생을 믿고 추천서 써줄 수 있을지 모르겠네요
10년 만에 학부 강의를 1개 들은 학생이 추천서 를 메일로 요청해 왔습니다.
12 - 말씀들 감사합니다. 냉정하게 생각하면 안 쓰는 게 맞는데, 어쨌든 수강 기록이 있으니 그 정도라도 적었어야 하나 고민했었습니다.
기업은 아니고 국내 대학원인데 (크게 경쟁이 없는), 그냥 구색 맞추기 서류여서요. 사실 아는 게 없으니 안 적는게 맞지만, 예전 그래도 몇 자 적어주자 문화에 길들여져 있었나 봅니다. 그 분께는 작성할 수 없다고 답을 했습니다.
10년 만에 학부 강의를 1개 들은 학생이 추천서 를 메일로 요청해 왔습니다.
12 - 60 받고 석사 생활한 사람으로써, 돈이 목적이면 그냥 취업하는게...먹고사는거 당연히 중요하지만 자꾸 대학원생활 이야기하며 돈 이야기하는건 분명 주위에 취업한 친구보고 '쟨 얼마 버는데..' 비교에서 시작한다고 봄..
그게 부러우면 취업하면 되지, 왜 대학원 왔지?
나중에 박사하고 정출연을 가던 교수를 가더라도 대기업 간 친구들하고 또 비교하게됨...
'쟤들은 성과금 알마받더라..'
스스로 특정 분야에서 성취감을 느끼며 자존감을 올려야지, 돈이 목적이면 공부 하지 않는게 나을듯...
이공계 석사 인건비 평균일까요?
8
추석 연휴에 연락오는 교수님...
2025.10.07
다른랩도 일상인가요? 허허..많이 당황스러웠습니다
-
106 10 12994 -
5 14 7019 -
35 43 21835
교수님이 너무 좋아요 김GPT 21 19 12785
교수님과의 관계, 연구에 영향 김GPT 9 18 4913
교수님도 교수님 인생이 있으시겠죠 김GPT 0 0 1071-
4 3 4058
저는 파트타임 호구입니다. 김GPT 12 4 2515
교수님.. 김GPT 3 0 1134
나는 포항살이 대만족 명예의전당 153 81 60278-
277 35 44412 -
80 62 18403
베스트 최신 글
- 나라에서 여러 과기원들을 만들어준게 너무 감사하네요
3118 - 10년 만에 학부 강의를 1개 들은 학생이 추천서 를 메일로 요청해 왔습니다.
13470 - n개월째 방치 중인 학부연구생, 이대로 탈출해도 될까요?
3330 - 카이스트 컨택을 못했는데 합격 가능성이 있을까요? 조언 부탁드립니다..!
2712 - 이공계 석사 인건비 평균일까요?
4966 - ICML 2026
3603 - 교수새키 애들 속이는거 너무 못됫음
8438 - 여기서보면 나만 대충살았나 싶다 ㅋㅋㅋ
4578 - 좋은 랩인 것 같은데 주변에서 학벌 더 높이는 것이 어떠냐 합니다
7361 - 학교 오래다니는데 언제 졸업하나 물어보시는 교수님
4609
베스트 최신 글
- 포스텍 서류 컷
4040 - 미국 유학 11년 차
4171 - 1년차 박사과정인데 어머니가 아프시다는 소식을 들었습니다
10875 - 박사 진학 시 동일 학교&학과에서 지도교수를 바꾸는 것.. 실례되는 행동인가요
4285 - 지방대에서 꾸역꾸역 대학원 왔는데
9888 - 교수님이 좋은데요.. 20살 가까이 차이 나는 학생이 좋아하면 불쾌하실까요?
7185 - 나이 40 넘고 서울대 전기정보 공학부 대학원에 진학이 가능한가요?
5255 - 석사과정 2년 결론 : MBTI는 과학이다
13905 - 대학원을 너무 만만하게 보고 인생을 제손으로 꼰 것 같네요
15185 - 카이스트 학점을 많이 본다는 게 정설인가요?
5201
🔥 시선집중 핫한 인기글
- 실패한 사람들 얘기는 어디에도 없구나
78 - 연대가 포스텍보다 더 낫다는 애들은 정신병자임?
98 - 박사졸업을 앞두고 더 일찍알았으면 더 잘할수있을텐데 싶은 것들
277 - 김박사넷 블라인드 펌글
130 - 후배들의 진로 선택과 균형된 정보 획득을 위해 익명의 힘을 빌어 다 같이 연봉 공개 타임 한번 갖는 것 어때요?
80 - 좋은 랩인 것 같은데 주변에서 학벌 더 높이는 것이 어떠냐 합니다
19 - 여기서보면 나만 대충살았나 싶다 ㅋㅋㅋ
14 - 제가 너무 못난것같습니다.
7 - 나이많은 교수들 여학생이라고 과잉배려좀 하지마라
8 - 논문 7개
6 - 자대생인데 다른 연구실 겨수님들이 맨날 괜찮냐고 물어보십니다
4 - 나라에서 여러 과기원들을 만들어준게 너무 감사하네요
24 - 7개 물리논문
10
최근 댓글이 많이 달린 글
- [무료] 2026 미국 대학원 유학 준비 스타터팩 이벤트
224 - HCI 분야쪽 석사 막학기입니다. 지도교수님께서 미국 박사를 가보라고 말씀해주셨습니다. 현실적으로 제가 갈 수 있는지 잘 모르겠네요.
6 - 1년차 박사과정인데 어머니가 아프시다는 소식을 들었습니다
25 - 대학원 간판 (명성/인지도) vs. 연구주제 (research fit)
29 - Ai 박사 어디가 좋을까요 (ut austin VS 조지아텍 VS Columbia VS UMich)
11 - ICML 2026
25 - 교수새키 애들 속이는거 너무 못됫음
24 - 이공계 석사 인건비 평균일까요?
27 - 대학원 텃세 어떻게 버티나요 ㅠㅠ
8 - 10년 만에 학부 강의를 1개 들은 학생이 추천서 를 메일로 요청해 왔습니다.
8 - 교수 배때지 기름낀 찐따새끼
5 - 대학원 파트타임으로 다니고 있는데 학부생이 수업함.
12 - 교수들 왜이리 허풍이 심하죠
5

2025.10.08
2025.10.08
2025.10.08
2025.10.08
대댓글 1개